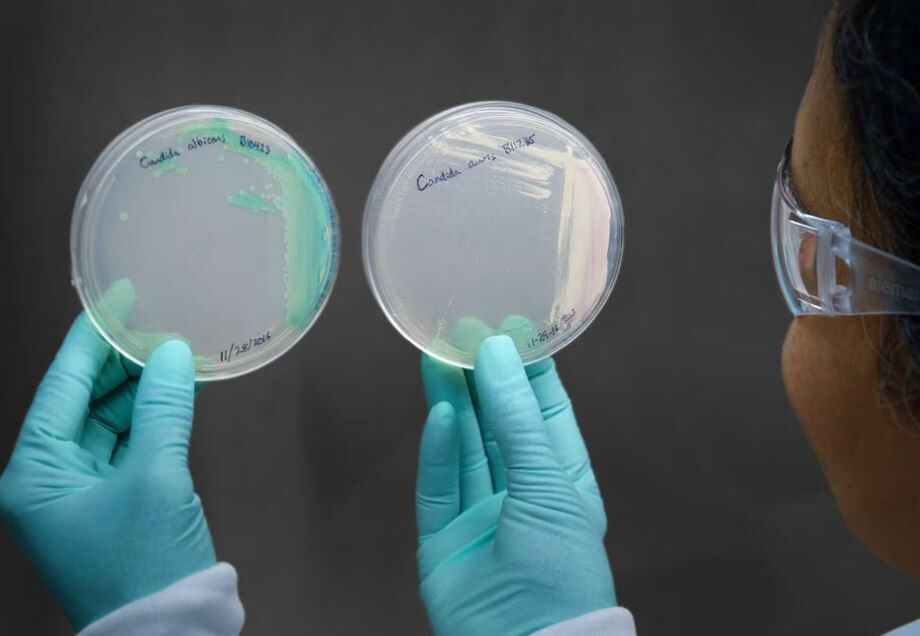

São Paulo confirmou nesta quarta-feira, 7, o primeiro caso de contaminação pelo superfungo Candida auris no Estado. A doença, registrada em 18 de maio, foi diagnosticada em um bebê prematuro que está internado no Hospital da Mulher da Universidade de Campinas (Unicamp), o Caism, no interior paulista.

Em nota, o Caism informa que o bebê infectado apresenta boa evolução clínica, e que algumas das fragilidades encontradas no seu estado de saúde estão relacionadas ao fato da criança ter nascido de forma prematura.
O hospital afirmou também que, até o momento, a contaminação pelo Candida auris não atingiu outros pacientes do hospital, e que continua monitorando outros internados para se certificar que não há outras infecções pelo superfungo na unidade.
Foi adotada, de acordo com o hospital da Unicamp, a metodologia de precaução de contato para os pequenos que foram atendidos por médicos que tiveram contato o caso fonte. "Iniciar essa medida frente à simples hipótese de infecção ajuda a conter a disseminação de patógenos e a proteger pacientes e profissionais da saúde", afirmou o Caism.
Medidas de prevenção e controle da doença foram adotadas pelo hospital, como: limpeza concorrente (isto é, na presença do paciente) do local de internação no mínimo a cada 3 horas, desinfecção dos equipamentos médico-hospitalares; orientação às equipes sobre as técnicas adequadas de higienização das mãos e de paramentação; realização de limpeza; e redução do número de visitas ao caso fonte.
"Esse caso já foi notificado às autoridades sanitárias competentes, que o incluirão em seus próximos boletins sobre a Candida auris", informou o Caism.
Por meio de nota a outros veículos de imprensa, a Secretaria de Saúde do Estado informou que o hospital implementou "todas as medidas de prevenção e controle" sobre a doença, e que a Vigilância Sanitária monitora as estratégias adotadas pela unidade. Ainda segundo a pasta, o hospital está liberado para fazer partos e atendimentos a pacientes.
Alta letalidade e capacidade de resistência
Uma característica da Candida auris é alta letalidade e a capacidade de resistir aos remédios usados para combater o agente patológico. Há várias linhagens do fungo, e algumas são imunes a todas as três classes de remédios existentes. E embora os meios de transmissão sejam incertos, a contaminação dentro de hospitais é um traço comum no histórico do superfungo.
No Brasil, onde o primeiro caso foi detectado em 2020, já foram registrados três surtos da doença: dois em Salvador, na Bahia, e um, e mais recente, no Recife, em Pernambuco. Todos aconteceram dentro de unidades hospitalares. O terceiro surto foi o mais severo, atingindo 48 pessoas entre novembro de 2021 e fevereiro de 2022.
Os casos voltaram a surgir este ano. No último 11 de maio, a confirmação de um diagnóstico positivo para a doença levou o hospital estadual Miguel Arraes, da cidade Paulista, na região metropolitana de Recife, suspender o recebimento de novos pacientes na unidade. Três dias depois, um paciente que estava internado em um hospital da capital pernambucana também foi contaminado. No caso, somente a ala onde ele estava foi isolada.
De lá para cá, outras pessoas foram positivadas, e fazem o Estado nordestino somar, até esta quarta-feira, 7, nove confirmações de contaminados para C. auris.
A alta letalidade, inclusive, pode estar relacionada justamente ao fato de o fungo contaminar pacientes hospitalizados que já estão com a saúde fragilizada. Segundo agências de saúde como o Centro de Controle e Prevenção de Doenças, do governo dos Estados Unidos (CDC, na sigla em inglês), a taxa de mortalidade dos infectados chega a 60%.
"Candida auris é uma espécie de cândida caracterizada pela sua notável resistência ao antifúngicos. É uma levedura resistente a muitas drogas". diz o infectologista Flávio Teles, coordenador do Comitê de Micologia da Sociedade Brasileira de Infectologia (SBI), em um comentário gravado ao site da entidade.
"Essa espécie de cândida exige medidas rigorosas de controle porque é um agente transmissão hospitalar e difícil de ser eliminada", afirma o especialista.
O CDC informa que as principais medidas de prevenção e controle contra a C.Auris são a higienização das mãos (usar luvas não é suficiente) e a limpeza e desinfecção do local onde o paciente está internado, e dos equipamentos que serão utilizados novamente.



















